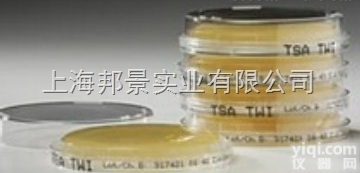
<em>葡萄糖</em>（<em>脑膜炎</em><em>奈瑟</em>氏菌专用）价格

葡萄糖(脑膜炎奈瑟氏菌专用) 生化管
- 产地:国产|进口
- 供应商:上海广锐生物科技有限公司
- 供应商报价:面议
- 标签:葡萄糖(脑膜炎奈瑟氏菌专用) 生化管,-1,上海广锐生物科技有限公司
| 品牌 | 自营品牌 | 货号 | 培养基 |
|---|---|---|---|
| 规格 | 支 | 供货周期 | 现货 |
| 主要用途 | 葡萄糖(脑膜炎奈瑟氏菌专用) 生化管 |
葡萄糖(脑膜炎奈瑟氏菌专用) 生化管 公司产品有干粉培养基、细菌微量生化管、配套试剂、药敏纸片、一次性成品培养基及试剂原料等。
1.规格:20支、9种*10支、11种*10支、16种*10支、13种*10支、20支/盒、9cm平板
2.库存均有现货,葡萄糖(脑膜炎奈瑟氏菌专用)可现做。
3.以库存产品价格为准。
4.出库前复检保证质量。
广锐生物不断开拓与创新,致力于“做好的培养基”,竭诚为广大国内外客户提供优质葡萄糖(脑膜炎奈瑟氏菌专用) 生化管
微生物干粉培养基:有细菌总数,大肠杆菌,金黄色葡萄球菌,沙门氏菌,霉菌酵母菌,李斯特菌等所有细菌的普通培养基和显色培养基。
一次性成品培养基的产品有:血琼脂平板、营养琼脂平板、伊红美蓝平板、SS平板、麦康凯平板、TSA平板,沙宝罗葡萄糖琼脂平板,显色培养基平板;
一次性管装培养基:乳糖胆盐管装培养基/10ML、硫乙醇酸盐管装培养基/50ML、改良马丁管装培养基/50ML等。
微生物生化管:大肠杆菌科生化管,沙门氏菌生化管等。
葡萄糖(脑膜炎奈瑟氏菌专用)同一批库存其他产品:
9028-88-0酶|乙醛脱氢酶
羊胆盐BR25g
3-乙基氨基-对甲苯酚98%500g
1-(2,4-二氯苯)哌98%500g
酪蛋白胨BR250g
猴子热休克蛋白糖蛋白96(HSPgp96)ELISA试剂盒厂家
屈螺酮In-houseStandard1g
呋喃妥因(呋喃旦啶)药敏纸片
14337-53-2色素|2-(5-溴-2-吡啶偶氮)-5-(二乙氨基)苯酚
56-53-1己烯雌酚,乙芪酚,乙烯雌酚,二羟二乙基代乙芪酚,二乙基二苯乙烯雌激酚,二乙基己烯雌酚,乙烯雌激酚,茋雌酚98对照品
BOC-D-3-(4-吡啶基)-丙氨酸96%1g
Humanimmunoglobulinheavychainvariableregion,IgHVELISAKit
6976-37-0缓冲剂|双[三(羟甲基)氨基甲烷]
2-氰基苯肼盐酸盐98%500g
异4B酸98%500g
4-氟-3-氯苯甲酸≥99.0%500g
2,2'-硫代二乙酸98%25g
氟苯尼考丁二酸钠98%500g
尿素琼脂培养基BR250g
TDBTU≥98%5g
(R)-(+)-2-溴-α-甲基苯甲醇98%5g
人幽门螺旋杆菌IgM(Hp-IgM)ELISA试剂盒
氘代正己烷-d1499%1g
156-57-0其他试剂|β-巯基乙胺盐酸盐
25296-54-2色素|酚酞络合指示剂
4-氨吡啶99%100g
三(4-吗啉代)膦98%5g
N/A甘草皂苷G2(24-氢氧甘草甜素)>98对照品
α-雌二醇98%1g
辛癸酸季戊四酯99%500ml
人1,3-βD葡葡糖苷酶(1,3-βDglucosidase)含量试剂盒
3-噻吩甲醇99%25g
犬尿氨酸98%500g
邻苯二甲酸二仲辛酯(DCP)99500ml
金属钾AR99%100g
锑粉CP250g
分离材料|透析袋20DM,25MD